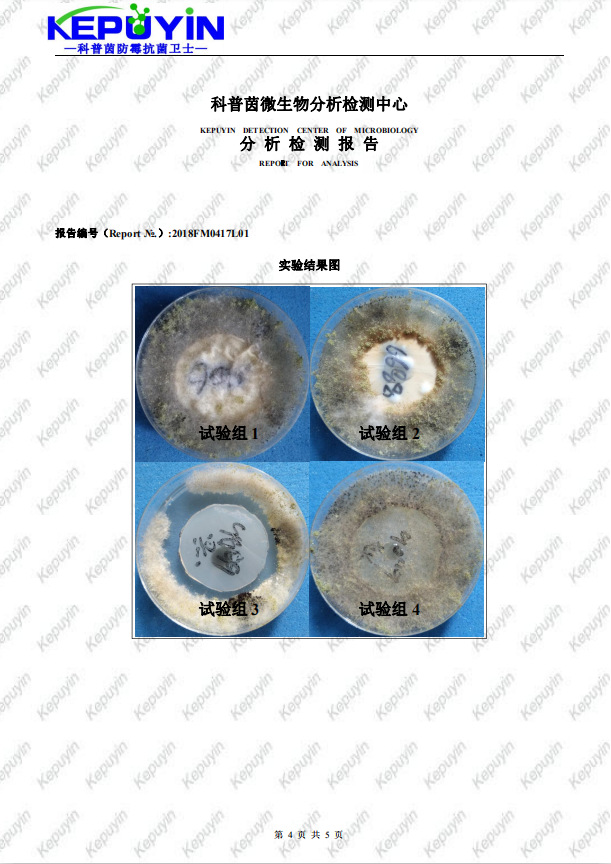
undefined

硅酮胶专用防霉剂PP-V100 日本进口琉璃胶密封胶MS胶防霉抗菌剂
- 供应商
- 佛山科普茵生物科技有限公司
- 认证
- 品牌
- 科普茵
- 型号
- PP-V100
- 产地
- 广东
- 联系电话
- 0757-88788686
- 手机号
- 18620907734
- 经理
- 陈师
- 所在地
- 佛山市南海区大沥镇盐步横江横沙路88号厂房的2楼(住所申报)
- 更新时间
- 2021-10-22 10:56


硅酮胶防霉抗菌剂PP-V100是原装进口的防霉抗菌剂,使用全新工艺设计,选取多种应用浓度下无毒,无刺激的原料反应复配而成,具有极高的安全性,和多数油性涂料或材料复配性良好,防霉效果卓越的特点;适用于处理绝大多数硅酮胶或改性硅酮胶产品任意阶段添加使用。对黑曲霉、黄曲霉、绿色木霉、球毛壳霉、白色念珠菌、金黄色葡萄球菌、大肠杆菌等数百种致病菌都有优异的杀灭作用。


*高效广谱,尤其对曲霉、青霉、毛霉、多数革兰氏阳性菌和革兰氏阴性菌有;
*便于使用,容易分散均匀;
*规定使用量下,对人体无刺激,无毒,2001年通过美国环境保护署;
*适用的pH范围广泛,2-10均可使用;
*耐高温300℃、耐老化、耐黄变、不挥发、抗流失;
*不影响胶的物理性能,不影响透明度、不影响固化速度、不影响储存时间。


硅酮胶防霉抗菌剂PP-V100可同时防霉、抗菌、抗藻,是工业领域十分有效的抗菌剂之一,添加到PVC制品、塑料制品、墙面涂料、海洋防污、涂料、油墨、纸张、电缆等内即可成防霉抗菌制品。

※聚氨酯,软PVC,聚烯烃,亚克力,苯乙烯,橡胶,有机硅化合物中,添加0.5~1%(O.W.F),即可制成防霉抗菌制品。对于户外乙烯树脂用品,建议添加到1.0%(O.W.F),以保证抗菌防霉效果。
※如胶黏剂、硅酮胶、涂料等加工过程中,添加0.3~0.5%(O.W.F),即可制成防霉抗菌制品。
※将防霉剂PP-V100和原料按以上用量混合后,充分搅拌均匀即可。

硅酮胶防霉抗菌剂PP-V100主要成分为中的活性组分与微生物细胞中酶的巯基(SH)配位结合,从而阻止微生物的代谢、杀灭细胞或孢子。辅助成分为非氧化性杀菌剂,其穿过细胞膜进入细胞,杂环上的活性部分与细菌体内的蛋白质作用使其键断开。也能与DNA结合,一方面阻断核酸的复制从而抑制微生物的繁殖,另一方面导致基因变异引起蛋白质的合成异常,Zui终导致细胞死亡。能够控制范围很广的真菌和细菌,还具有优异的杀藻性能。

安全数据
*大白鼠急性经口LD50 2000mg/kg。急性经皮LD50 5000mg/kg。
*对皮肤和眼睛有一定的刺激性和腐蚀性。
测试标准
* GBT1741-2007 漆膜耐霉菌性测定法
* JC/T885—2016 建筑用防霉密封胶
* ISO22196-2007 塑料制品表面抗菌性能评价方法
* GBT21866-2008 抗菌涂料(漆膜)抗菌性测定法和抗菌效果
*HGT3950-2007 抗菌涂料

注意事项
本品对易过敏者会造成眼睛和皮肤有刺激,使用操作时必须戴手套、防护口罩和护目镜,避免接触皮肤。一旦与皮肤和眼睛接触立即用大量清水及肥皂清洗并及时就医。
包装储存
包装及规格:化工塑料桶包装,25kg/桶。密封避光储存,储存温度低于40℃。




